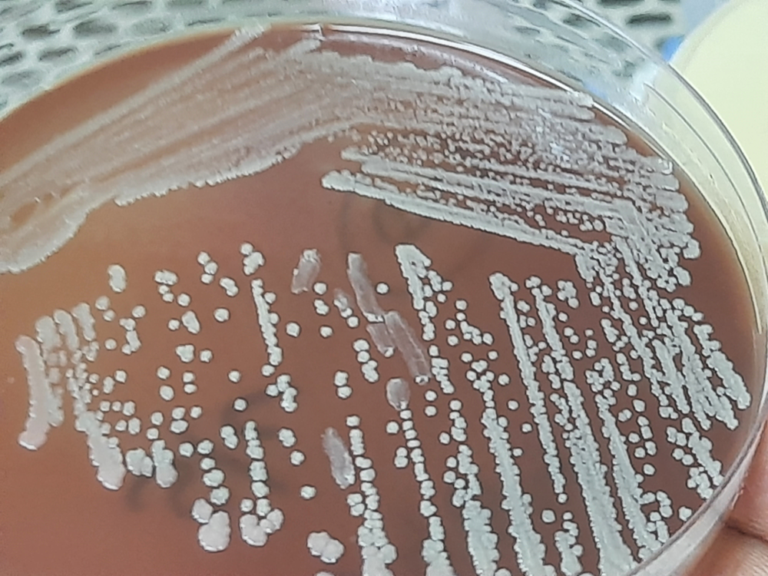

Blend: Ipamorelin CJC129 No DAC
Microbial Limits Testing for Research-Use Peptide Products
Author: Dr. Numan S. Date: December 25, 2025

Microbial Limits Testing for Research-Use Peptide Products
In research settings, microbial limits testing provides critical assurance that peptide materials meet defined microbiological thresholds without requiring full sterility. This approach is particularly important for research-use peptides that are handled, reconstituted, or stored under laboratory conditions where environmental exposure is possible. By confirming that total aerobic microbial counts and yeast and mold levels remain within acceptable limits, microbial limits testing supports consistent peptide quality control and helps ensure that experimental outcomes are influenced by the peptide itself rather than unintended microbial interference.
What Is Microbial Limits Testing?
Microbial limits testing is a quality control procedure that measures the bioburden of non-sterile products by counting viable microorganisms and detecting specific harmful microbes. Unlike sterility testing (which demands zero detectable microbes), microbial limits testing establishes acceptable thresholds for microbial presence [2]. The test typically involves two components: a total aerobic bacterial count and a total yeast and mold count, plus checks for any specified “objectionable” bacteria defined by standards [3]. It confirms that a peptide sample’s bioburden is below the allowable limit and that no dangerous pathogens are present.
Why Microbial Limits Testing Matters for Research-Use Peptides
Research peptides are often produced for laboratory experiments and are not always required to be sterile. However, ensuring they have minimal microbial contamination is critical. Bacteria or fungi in a peptide vial can produce enzymes or toxins that degrade the peptide or skew experimental results [3]. Even low-level contamination may render a peptide preparation unsuitable for reliable research, as microbial byproducts can disrupt sensitive biological assays.
Secondly, inconsistent microbial quality can undermine reproducibility. Experiments may fail if one peptide batch has a higher bioburden than another, so batch-to-batch microbial limits testing helps ensure each lot has similarly low contamination. Keeping microbial counts controlled across all batches means researchers won’t encounter unexpected variability due to contamination.

Figure 1: A petri dish showing microbial contamination by multiple bacteria and fungi colonies.
Microorganisms Evaluated in Microbial Limits Testing
Microbial limits testing includes quantitative enumeration of total viable aerobic bacteria and total combined yeasts and molds, providing an overall assessment of the product’s microbial bioburden. In addition to these general counts, the test incorporates targeted screening for specified objectionable microorganisms that pose elevated risks to research integrity and product stability. Regulatory and pharmacopeial guidelines typically require that non-sterile products contain no detectable colonies of certain pathogenic species, most commonly Escherichia coli, Salmonella spp., Staphylococcus aureus, and Pseudomonas aeruginosa due to their ability to proliferate rapidly, produce toxins, or degrade peptide structures. The absence of these organisms is verified using selective culture media and confirmatory identification methods. By combining total microbial enumeration with pathogen-specific detection, microbial limits testing delivers a comprehensive microbiological profile that helps ensure research-use peptide products remain suitable for controlled laboratory applications without introducing confounding biological variables.
Figure 2: Colonies of bacteria growing on an agar plate.
How Microbial Limits Testing Is Performed
Microbial limits testing is performed using standardized culture-based techniques designed to detect and quantify viable microorganisms present in non-sterile products. A defined quantity of the peptide material—either in solid form or after reconstitution—is aseptically transferred into suitable diluents and then introduced into nutrient media or passed through membrane filtration systems. The membranes or inoculated media are incubated under controlled conditions for several days to allow any viable bacteria, yeasts, or molds to proliferate into visible colonies. Colony-forming units (CFUs) are then counted to determine the total aerobic microbial count and the total yeast and mold count, which together reflect the product’s overall bioburden.
In parallel, targeted tests are conducted to detect specific objectionable microorganisms using selective enrichment broths and differential agar media. For example, samples may be incubated in selective media that promote the growth of Escherichia coli or Staphylococcus aureus while inhibiting non-target organisms. Presumptive positive results are confirmed through additional biochemical or morphological identification steps. All procedures are performed in accordance with established pharmacopeial methods to ensure reproducibility, sensitivity, and comparability between batches, making microbial limits testing a reliable component of routine peptide quality control.
How Microbial Limits Testing Is Performed
Microbial limits testing is performed using standardized culture-based techniques designed to detect and quantify viable microorganisms present in non-sterile products. A defined quantity of the peptide material—either in solid form or after reconstitution—is aseptically transferred into suitable diluents and then introduced into nutrient media or passed through membrane filtration systems. The membranes or inoculated media are incubated under controlled conditions for several days to allow any viable bacteria, yeasts, or molds to proliferate into visible colonies. Colony-forming units (CFUs) are then counted to determine the total aerobic microbial count and the total yeast and mold count, which together reflect the product’s overall bioburden.
In parallel, targeted tests are conducted to detect specific objectionable microorganisms using selective enrichment broths and differential agar media. For example, samples may be incubated in selective media that promote the growth of Escherichia coli or Staphylococcus aureus while inhibiting non-target organisms. Presumptive positive results are confirmed through additional biochemical or morphological identification steps. All procedures are performed in accordance with established pharmacopeial methods to ensure reproducibility, sensitivity, and comparability between batches, making microbial limits testing a reliable component of routine peptide quality control.
Microbial Limits Testing vs Other Quality Tests
Unlike a sterility test that demands total absence of growth, microbial limits testing allows a small, defined level of microorganisms [2]. Sterile, injectable-grade products therefore undergo formal sterility assays instead of microbial limits testing, whereas non-sterile research peptides rely on microbial limits tests as a key quality check. This distinction highlights that microbial limits testing is suited for research-use peptides and other non-sterile materials, ensuring they remain within safe microbial load limits while not requiring the absolute sterility of clinical products.
Best Practices for Manufacturers
Manufacturers of research-use peptides can employ several best practices to minimize microbial contamination as part of peptide quality control and to meet microbial limits. First, production and handling should occur in controlled environments – ideally in cleanrooms with HEPA filtration and strict hygiene – to minimize airborne microbes, coupled with active environmental monitoring to detect any spikes in contamination [4]. Second, rigorous cleaning and sanitation of equipment, containers, and work surfaces prevents carry-over of microbes between batches [6].

Figure 3: A contamination control engineer working in a cleanroom.
Another key practice is enforcing proper gowning and personnel hygiene – operators wear protective attire (gloves, masks, gowns, hair nets) and follow aseptic techniques to avoid shedding microorganisms into the processing area. Finally, manufacturers implement corrective action plans: if environmental or product testing shows elevated microbial counts, an investigation pinpoints the source (e.g. a cleaning lapse or equipment contamination) so it can be fixed promptly. By maintaining these preventive measures, companies keep microbial counts within acceptable limits batch after batch [4].
Microbial Limits Testing Protects Research Integrity and Product Quality
Microbial limits testing plays a critical role in safeguarding both research integrity and product quality by ensuring that peptide materials meet defined microbiological standards. When microbial bioburden is controlled, researchers can be confident that observed experimental outcomes are driven by the peptide itself rather than unintended microbial byproducts or enzymatic degradation. This reliability is particularly important in sensitive biological assays where even minor contamination can alter results.
When integrated with complementary quality measures such as analytical purity testing and endotoxin assessment, microbial limits testing supports a comprehensive quality assurance framework for research-use peptides. Maintaining consistent microbial control reduces batch variability, improves reproducibility, and minimizes experimental failure. Ultimately, microbial limits testing serves as a foundational component of peptide quality control, reinforcing trust in research materials and supporting high-quality scientific outcomes.
Frequently asked questions (FAQs) about Microbial Limits Testing for Research-Use Peptide Products
What does microbial limits testing measure?
- Microbial limits testing measures the total number of viable microorganisms present in a non-sterile product, typically reported as total aerobic microbial count (TAMC) and total yeast and mold count (TYMC). In addition to overall bioburden, the test also screens for the absence of specific objectionable microorganisms—such as Escherichia coli or Staphylococcus aureus—that could interfere with experimental systems. Together, these measurements provide a quantitative and qualitative assessment of microbial contamination risk in peptide materials.
How does microbial limits testing protect research outcomes?
- By confirming that microbial contamination remains below defined thresholds, microbial limits testing helps prevent confounding variables in sensitive biological assays. Excess bacteria or fungi can degrade peptides, alter pH, introduce endotoxins, or activate immune signaling pathways in cell-based or animal models. Controlling microbial load therefore supports experimental reproducibility, data integrity, and confidence that observed effects are attributable to the peptide itself rather than contamination artifacts.
When should peptide manufacturers perform microbial limits testing?
- Peptide manufacturers typically perform microbial limits testing on finished, non-sterile products before batch release, particularly for peptides intended for in vitro or preclinical research use. Testing is also commonly repeated after critical manufacturing steps, formulation changes, or extended storage to ensure microbial levels remain within acceptable limits over the product lifecycle. Routine, batch-level testing is a core component of good quality control practice.
How should researchers interpret microbial limits results?
- Researchers should interpret microbial limits results by comparing reported colony-forming unit (CFU) values against established acceptance criteria and confirming the absence of specified pathogens. Results well below the defined limits indicate low bioburden and reduced contamination risk, while values approaching limits may warrant additional handling precautions. Results exceeding limits suggest potential compromise of sample integrity and should prompt investigation, retesting, or rejection of the material for sensitive experimental work.
How does microbial limits testing fit into broader quality programs?
- Microbial limits testing functions as one element within a comprehensive quality framework that may also include endotoxin testing, sterility testing (when applicable), analytical purity assessment, and environmental monitoring. When integrated with documented manufacturing controls and batch records, microbial limits data help demonstrate consistent process control and overall product reliability. This layered quality approach is essential for supporting reproducible research and maintaining confidence in peptide manufacturing standards.
References
- BA Sciences. Sterile vs Non-Sterile Testing: Requirements for Pharmaceutical Quality. November 10, 2025.
https://basciences.com/resources/sterile-vs-non-sterile-testing - U.S. Food and Drug Administration (FDA). Q6A: Specifications – Test Procedures and Acceptance Criteria for New Drug Substances and New Drug Products: Chemical Substances. 2000.
https://www.fda.gov/regulatory-information/search-fda-guidance-documents/q6a-specifications-test-procedures-and-acceptance-criteria-new-drug-substances-and - BA Sciences. USP <61> Microbiological Examination of Nonsterile Products. Company website. Accessed December 2025.
https://basciences.com/resources/usp-61-microbiological-examination-nonsterile-products - Contract Laboratory. COA Testing for Research Peptides. Project Request. May 30, 2025.
https://www.contractlaboratory.com/labclass/services/cofa.cfm - R&D World. Controlling Endotoxin Contamination During Peptide Manufacturing. 2012.
https://www.rdworldonline.com/controlling-endotoxin-contamination-during-peptide-manufacturing/
